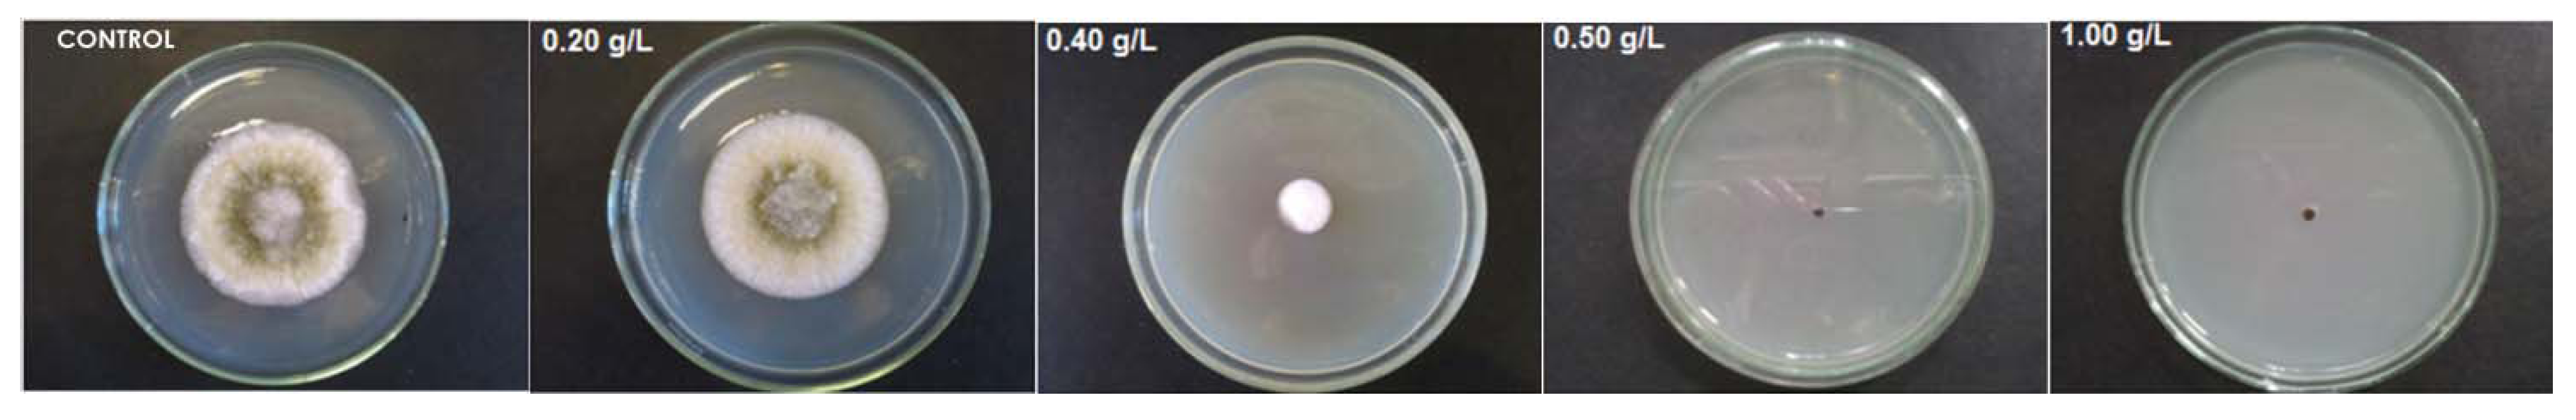

Hydrophobic Effect of Amphiphilic Derivatives of Chitosan on the Antifungal Activity against Aspergillus flavus and Aspergillus parasiticus
Abstract
:1. Introduction

2. Results and Discussion
2.1. Synthesis and Characterization of the Amphiphilic Derivatives
2.2. Antifungal Activity of Deacetylated Chitosan and Its Amphiphilic Quaternary Derivatives

| Derivative | Dod/NH2 ratio | [η] (mL/g) | Mv (g/mol) ×103 | DS2(%) ** Dod groups |
|---|---|---|---|---|
| CH | - | 267.7 | 27.2 | |
| CH-Pr80 * | - | 101.3 | 8.1 | - |
| Dod10-CH-Pr80 | 0.10 | 8.3 | ||
| Dod15-CH-Pr80 | 0.15 | 14.1 | ||
| Dod30-CH-Pr80 | 0.30 | 29.0 | ||
| CH-Pr50 * | - | 142.6 | 12.3 | - |
| Dod5-CH-Pr50 | 0.10 | 7.1 | ||
| Dod15-CH-Pr50 | 0.15 | 9.4 | ||
| Dod30-CH-Pr50 | 0.30 | 27.1 |

| Derivative | MIC Concentration (g.L−1) | |||
|---|---|---|---|---|
| Aspergillus flavus | Aspergillus parasiticus | |||
| 48 h | 72 h | 48 h | 72 h | |
| CH | >4.0 | >4.0 | >4.0 | >4.0 |
| Dod10CHPr50 | 0.125 | 1.0 | 0.125 | 0.50 |
| Dod15CHPr50 | 0.125 | 1.0 | 0.125 | 0.250 |
| Dod30CHPr50 | 0.125 | 1.0 | 0.125 | 0.250 |
3. Experimental
3.1. Materials
3.2. Instrumentation
3.3. Synthesis of the Amphiphilic Propyltrimethylammonium-Modified Chitosans
3.4. Characterization
3.4.1. FTIR Analysis
3.4.2. Determination of the Degrees of Substitution DS1 and DS2 by 1H-NMR Spectroscopy
3.4.3 Viscosity Measurements.
3.5. Pathogen and Cultures
3.6. Antifungal Assays
3.7. Minimum Inhibitory Concentrations (MICs)
4. Conclusions
Supplementary Materials
Acknowledgments
References
- Vinsova, J.; Vavrikova, E. Chitosan derivatives with antimicrobial, Antitumour and antioxidant activities—A review. Curr. Pharm. Design 2011, 17, 3596–3607. [Google Scholar] [CrossRef]
- Sajomsang, W. Synthetic methods and applications of chitosan containing pyridylmethyl moiety and its quaternized derivatives: A review. Carbohyd. Polym. 2010, 80, 631–647. [Google Scholar] [CrossRef]
- Fu, X.; Shen, Y.; Jiang, X.; Huang, D.; Yan, Y. Chitosan derivatives with dual-antibacterial functional groups for antimicrobial finishing of cotton fabrics. Carbohyd. Polym. 2011, 85, 221–227. [Google Scholar] [CrossRef]
- Rúnarsson, Ö.V.; Holappa, J.; Malainer, C.; Steinsson, H.; Hjálmarsdóttir, M.; Nevalainen, T.; Másson, M. Antibacterial activity of N-quaternary chitosan derivatives: Synthesis, Characterization and structure activity relationship (SAR) investigations. Eur. Polym. J. 2010, 46, 1251–1267. [Google Scholar] [CrossRef]
- Kong, M.; Chen, X.G.; Xing, K.; Park, H.J. Antimicrobial properties of chitosan and mode of action: A state of the art review. Int. J. Food Microbiol. 2010, 144, 51–63. [Google Scholar] [CrossRef]
- Xu, J.; Zhao, X.; Han, X.; Du, Y. Antifungal activity of oligochitosan against Phytophthora capsici and other plant pathogenic fungi in vitro. Pest. Biochem. Physiol. 2007, 87, 220–228. [Google Scholar] [CrossRef]
- Belalia, R.; Grelier, S.; Benaissa, M.; Coma, V. New bioactive biomaterials based on quaternized chitosan. J. Agric. Food Chem. 2008, 56, 1582–1588. [Google Scholar] [CrossRef]
- Seyfarth, F.; Schliemann, S.; Elsner, P.; Hipler, U.-C. Antifungal effect of high- and low-molecular-weight chitosan hydrochloride, Carboxymethyl chitosan, Chitosan oligosaccharide and N-acetyl-d-glucosamine against Candida albicans, Candida krusei and Candida glabrata. Int. J. Pharm. 2008, 353, 139–148. [Google Scholar]
- Mohamed, N.A.; Abd El-Ghany, N.A. Preparation and antimicrobial activity of some carboxymethyl chitosan acyl thiourea derivatives. Int. J. Biol. Macromol. 2012, 50, 1280–1285. [Google Scholar] [CrossRef]
- Li, M.; Chen, X.; Liu, J.; Zhang, W.; Tang, X. Molecular weight-dependent antifungal activity and action mode of chitosan against Fulvia fulva (cooke) ciffrri. J. Appl. Polym. Sci. 2011, 119, 3127–3135. [Google Scholar] [CrossRef]
- Rabea, E.I.; Badawy, M.E.I; Rogge, T.M.; Stevens, C.V.; Höfte, M.; Steurbaut, W.; Smagghe, G. Insecticidal and fungicidal activity of new synthesized chitosan derivatives. Pest. Manag. Sci. 2005, 61, 951–960. [Google Scholar] [CrossRef]
- Sajomsang, W.; Tantayanon, S.; Tangpasuthadol, V.; Daly, W.H. Quaternization of N-aryl chitosan derivatives: Synthesis, Characterization, and antibacterial activity. Carbohyd. Res. 2009, 344, 2502–2511. [Google Scholar] [CrossRef]
- Zheng, L.-Y.; Zhu, J.-F. Study on antimicrobial activity of chitosan with different molecular weights. Carbohyd. Polym. 2003, 54, 527–530. [Google Scholar] [CrossRef]
- Amaike1, S.; Keller, N.P. Aspergillus flavus. Annu. Rev. Phytopathol. 2011, 49, 1–10. [Google Scholar] [CrossRef]
- Pedro, R.O.; Takaki, M.; Gorayeb, T.C.C.; Del Bianchi, V.L.; Thomeo, J.C.; Tiera, M.J.; Tiera, V.A.O. Synthesis, Characterization and antifungal activity of quaternary derivatives of chitosan on Aspergillus flavus. Microbiol. Res. 2013, 168, 50–55. [Google Scholar]
- Tiera, M.J; Qiu, X.P.; Bechaouch, S.; Shi, Q.; Fernandes, J.C.; Winnik, F.M. Synthesis and characterization of phosphorylcholine-substituted chitosans soluble in physiological pH conditions. Biomacromolecules 2006, 7, 3151–3156. [Google Scholar]
- Xu, T.; Xin, M.; Li, M.; Huang, H.; Zhou, S.; Liu, J. Synthesis, Characterization, and antibacterial activity of N,O-quaternary ammonium chitosan. Carbohyd. Res. 2011, 346, 2445–2450. [Google Scholar] [CrossRef]
- Guo, Z.Y.; Xing, R.; Liu, S.; Zhong, Z.; Ji, X.; Wang, L.; Li, P. The influence of the cationic of quaternized chitosan on antifungal activity. Int. J. Food Microbiol. 2007, 118, 214–217. [Google Scholar] [CrossRef]
- Cota-Arriola, O.; Cortez-Rocha, M.O.; Rosas-Burgos, E.C.; Burgos-Hernandez, A.; Lopez-Franco, Y.L.; Plascencia-Jatomea, M. Antifungal effect of chitosan on the growth of Aspergillus parasiticus and production of aflatoxin B1. Polym. Int. 2011, 60, 937–944. [Google Scholar] [CrossRef]
- Zhang, B.; Wang, D.-F.; Li, H.-Y.; Xu, Y.; Zhang, L. Preparation and properties of chitosan–soybean trypsin inhibitor blend film with anti-Aspergillus flavus activity. Ind. Crops Prod. 2009, 29, 541–548. [Google Scholar] [CrossRef]
- Jagadish, R.S.; Divyashree, K.N.; Viswanath, P.; Srinivas, P.; Raj, B. Preparation of N-vanillyl chitosan and 4-hydroxybenzyl chitosan and their physico-mechanical, Optical, Barrier, And antimicrobial properties. Carbohyd. Polym. 2012, 87, 110–116. [Google Scholar] [CrossRef]
- Rosas-Burgos, E.C.; Cortez-Rocha, M.O.; Cinco-Moroyoqui, F.J.; Robles-Zepeda, R.E.; López-Cervantes, J.; Sánchez-Machado, D.I.; Lares-Villa, F. Antifungal activity in vitro of Baccharis glutinosa and Ambrosia confertiflora extracts on Aspergillus flavus, Aspergillus parasiticus and Fusarium verticillioides. World J. Microbiol. Biotechnol. 2009, 25, 2257–2261. [Google Scholar] [CrossRef]
- Sajomsang, W.; Gonil, P.; Saesoo, S.; Ovatlarnporn, C. Antifungal property of quaternized chitosan and its derivatives. Int. J. Biol. Macromol. 2012, 50, 263–269. [Google Scholar] [CrossRef]
- Carolyn, R.; Lee, A.; Hadwiger, A. The fungicidal effect of chitosan on fungi of varying cell wall composition. Exp. Mycol. 1979, 3, 285–287. [Google Scholar] [CrossRef]
- Viera, D.B; Carmona-Ribeiro, A.M. Cationic lipids and surfactants as antifungal agents: Mode of action. J. Antimicrob. Chemoth. 2006, 58, 760–767. [Google Scholar]
- Guo, Z.Y.; Chen, R.; Xing, R.; Liu, S.; Yu, H.; Wang, P. Novel derivatives of chitosan and their antifungal activities in vitro. Carbohyd. Res. 2006, 341, 351–354. [Google Scholar] [CrossRef]
- Yang, T.C.; Chou, C.C.; Li, C.F. Antibacterial activity of N-alkylated disaccharide chitosan derivatives. Int. J. Food Microbiol. 2005, 97, 237–245. [Google Scholar] [CrossRef]
- Li, P.; Poon, Y.F.; Li, W.; Zhu, H-Y.; Yeap, S.H.; Cao, Y.; Qi, X.; Zhou, C.; Lamrani, M.; Beuerman, R.W.; et al. A polycationic antimicrobial and biocompatible hydrogel with microbe membrane suctioning ability. Nat. Mater. 2011, 10, 149–156. [Google Scholar] [CrossRef]
- Schmidtchen, A.; Pasupuleti, M.; Morgelin, M.; Davoudi, M.; Alenfall, J.; Chalupka, A.; Boosting, M.M. Antimicrobial peptides by hydrophobic oligopeptide end tags. J. Biol. Chem. 2009, 284, 17584–17594. [Google Scholar] [CrossRef]
- Roberts, G.A.F.; Wang, W. Evaluation of Mark-Houwink viscosimetric constants for chitosan. In Advances in Chitin Science; Martin, G.P., Domard, A., Muzzarelli, R.A.A., Eds.; Jacques Andre Publisher: Lyon, France, 1996; pp. 279–284. [Google Scholar]
- Clinical And Laboratory Standards Institute (CLSI), Reference Method for Broth Dilution Antifungal Susceptibility Testing of Filamentous Fungi; In Approved Standard—Second Edition, CLSI document M38-A2 (ISBN 1–56238–668–9); CLSI: Wayne, PA, USA, 2008.
- Sample Availability: Samples of the compounds CH-Pr50, Dod10CHPr50, Dod15CHPr50 and Dod15CHPr50 are available from the authors.
© 2013 by the authors; licensee MDPI, Basel, Switzerland. This article is an open access article distributed under the terms and conditions of the Creative Commons Attribution license (http://creativecommons.org/licenses/by/3.0/).
Share and Cite
Viegas de Souza, R.H.F.; Takaki, M.; De Oliveira Pedro, R.; Dos Santos Gabriel, J.; Tiera, M.J.; De Oliveira Tiera, V.A. Hydrophobic Effect of Amphiphilic Derivatives of Chitosan on the Antifungal Activity against Aspergillus flavus and Aspergillus parasiticus. Molecules 2013, 18, 4437-4450. https://doi.org/10.3390/molecules18044437
Viegas de Souza RHF, Takaki M, De Oliveira Pedro R, Dos Santos Gabriel J, Tiera MJ, De Oliveira Tiera VA. Hydrophobic Effect of Amphiphilic Derivatives of Chitosan on the Antifungal Activity against Aspergillus flavus and Aspergillus parasiticus. Molecules. 2013; 18(4):4437-4450. https://doi.org/10.3390/molecules18044437
Chicago/Turabian StyleViegas de Souza, Ricchard Hallan Felix, Mirelli Takaki, Rafael De Oliveira Pedro, Juliana Dos Santos Gabriel, Marcio José Tiera, and Vera Ap. De Oliveira Tiera. 2013. "Hydrophobic Effect of Amphiphilic Derivatives of Chitosan on the Antifungal Activity against Aspergillus flavus and Aspergillus parasiticus" Molecules 18, no. 4: 4437-4450. https://doi.org/10.3390/molecules18044437
APA StyleViegas de Souza, R. H. F., Takaki, M., De Oliveira Pedro, R., Dos Santos Gabriel, J., Tiera, M. J., & De Oliveira Tiera, V. A. (2013). Hydrophobic Effect of Amphiphilic Derivatives of Chitosan on the Antifungal Activity against Aspergillus flavus and Aspergillus parasiticus. Molecules, 18(4), 4437-4450. https://doi.org/10.3390/molecules18044437
